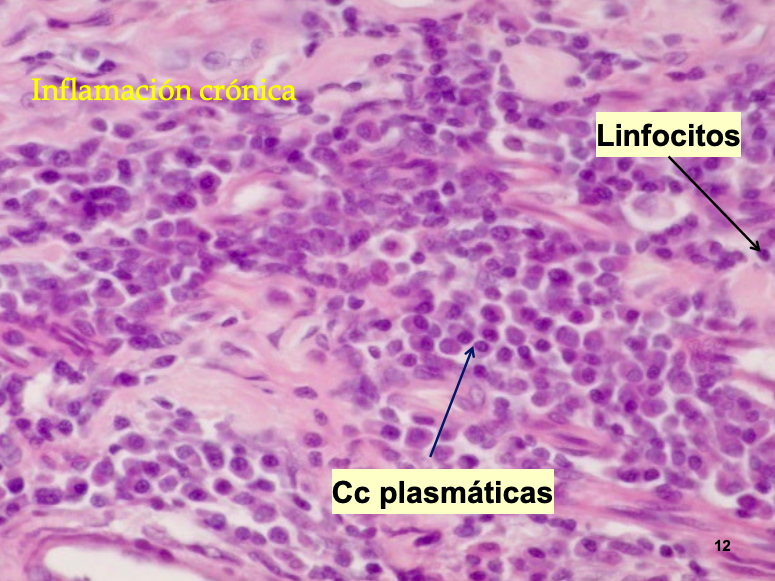
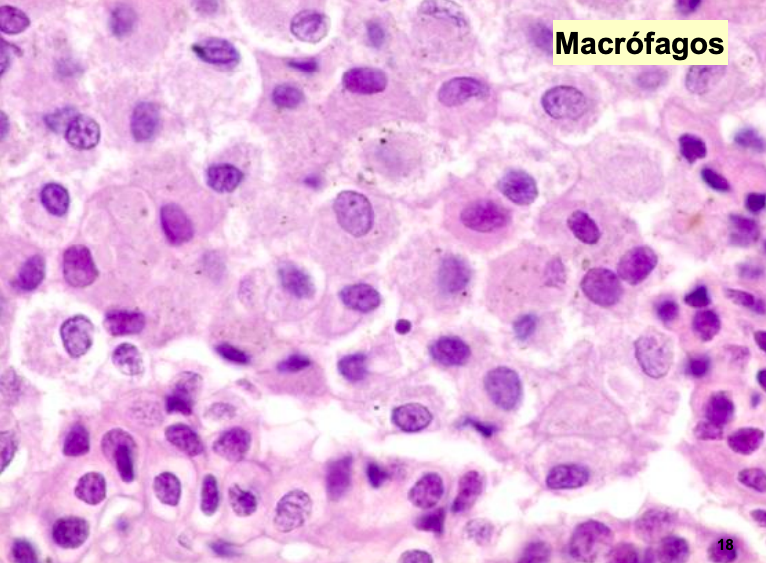

Tema 23 y 24 - Inflamación cronica - 17/11
Clase del / Presentación
INFLAMACIÓN CRÓNICA
Concepto. Etiología
Patrones morfológicos de la inflamación crónica:
- Inflamación granulomatosa
- Inflamación no granulomatosa
Concepto general
Inflamación de larga duración donde coexisten los siguientes fenómenos:
- Fenómenos inflamatorios activos: Infiltrado de células mononucleares (Macrofagos sobre todo)
- Destrucción tisular: Debido a la acción del infiltrado inflamatorio. Poca o mucha siempre existe.
- Fenómenos reparativos: Depósito de tejido conjuntivo y proliferación de neovasos. (El tejido crece en tamaño)
- NO neutrofilos como en infecciones agudas sino mononucleados
Desarrollo
La inflamación crónica puede:
- Establecerse de forma insidiosa, como una respuesta de baja intensidad, a menudo asintomática, ya desde el principio.
- Ser consecuencia de una inflamación aguda.
A medida que el exudado de la inflamación aguda disminuye se evidencian los procesos de reparación:
- Fagocitosis de restos celulares por macrófagos
- Invasión de capilares → intercambio sangre-tejido
- Invasión de fibroblastos → colágeno
Etiología o causas
Tienen en común ser estímulos persistentes que no pueden ser eliminados:
-
Infecciones persistentes:
- Microorganismos de baja patogenicidad que inducen mecanismos de hipersensibilidad retardada.
- Poseen gran capacidad de replicación o el organismo no puede eliminarlos: micobacterias, brucela, retrovirus, parásitos, hongos (aspergilus)...
-
Exposición prolongada a agentes potencialmente tóxicos:
- Agentes exógenos difícilmente degradables. Inertes pero de difícil eliminación. Inhalación.
-
Enfermedades autoinmunes:
- Reacción contra autoantígenos (artritis reumatoide...).
- Respuesta amplia y de larga duración.
-
Inflamación aguda que no cura adecuadamente
- Interferencias en el proceso de curación normal → inflamación crónica.
La inflamación crónica es la base lesional de algunas de las enfermedades más incapacitantes y comunes.
Inflamación Aguda (recordatorio)
- Respuesta inmediata frente a una agresión.
- Predominio de fenómenos vasculares (arteriolas–capilares–vénulas).
- Signos cardinales: calor, rubor, tumor, dolor, alteración de la función.
Cambios vasculares
Cambios celulares
MACROSCOPÍA
- Inflamación crónica: No fenómenos vasculares; predominan fenómenos proliferativos.
- Tejido engrosado de forma difusa (PTBC) o nodular (TBC).
Ejemplos (imágenes):
- Neumonía aguda vs Neumonía crónica
- Enteritis aguda vs Enteritis crónica
- Artritis aguda vs Artritis crónica
MICROSCOPÍA — Inflamación crónica
- Inflamación activa: infiltrado de células mononucleares (macrófagos, linfocitos, células plasmáticas).
- Destrucción tisular (mayor o menor, pero casi siempre presente).
- Intentos de reparación: fibroblastos, fibras y matriz extracelular sustituyen tejido lesionado.
- Presencia de neovasos (angiogénesis).
- Los cristales son calcio, comunes en inflamación cronica
Inflamación crónica: concepto
- Inflamación activa
- Destrucción tisular
- Intentos de reparación (fibrosis)
(Imágenes: células plasmáticas, linfocitos)
Ejemplos morfológicos
- Necrosis → destrucción tisular
- Reparación → sustitución por tejido conjuntivo → fibrosis
Células en la inflamación crónica
1) Macrófagos (Mononuclear)
- Principal célula de la inflamación crónica.
- Origen: médula ósea → monocito → macrófago.
- Mecanismos de migración iguales que en inflamación aguda (adhesión, quimiotaxis).
- A las 48–72 h ya son predominantes.
En inflamación aguda:
- Se destruyen o migran a linfonodos.
En inflamación crónica persisten por:
- Reclutamiento continuado de monocitos. Se expresan los factores quimitoaxicos y expresion de moleculas de adhesion
- División de macrófagos
- Inmovilización en la zona (citoquinas)
Activación por:
- Citoquinas (IFN-γ) → linfocitos
- Toxinas bacterianas, fibronectina…
Consecuencias de la activación:
- Aumentan de tamaño
- Metabolismo más activo
- ↑ enzimas lisosomales
- ↑ fagocitosis
- ↑ destrucción de microorganismos
Pero los productos segregados → destrucción tisular, proliferación vascular y fibrosis.
2) Linfocitos y células plasmáticas
Linfocitos: (Mononuclear)
- Se movilizan al reconocer antígeno presentado por CPA.

- Secretan citoquinas → activan macrófagos (IFN-γ).
- Macrófagos → IL-1, TNF → activan linfocitos → perpetúan inflamación.
Células plasmáticas:
- Elaboran anticuerpos contra el antígeno persistente o tejidos alterados.
(Imágenes de células presentadoras de antígenos)


3) Eosinófilos
(Imágenes: neumonía verminosa)
IMPORTANTE: Los parasitos buscan oxigeno, las bacterias lo huyen a los virus les da igual Bacterias: Craneoventral Virus: Neumonias difusas Caudodorsal: Parasitos
4) Neutrófilos
- Típicos de inflamación aguda.

- También presentes en inflamación crónica por ciertos agentes bacterianos.
- Atraídos por mediadores de macrófagos o células necróticas (necrotaxia).
INFLAMACIÓN CRÓNICA GRANULOMATOSA
Predominio de macrófagos. Muy comun en tuberculosis
Formas:
- Nodular (TBC)
- Difusa (PTBC)
Granuloma:
- Acúmulo de macrófagos y células epitelioides.
- Corona de linfocitos y ocasionalmente plasmáticas.
- Anillo externo de fibroblastos y tejido conjuntivo.
Célula epitelioide: macrófago transformado, poca capacidad fagocítica, destruye por secreción. Exclusiva de granulomas.
(Imágenes: granulomas, TBC perlada)







Tipos de granulomas (según etiología)
-
Granulomas por cuerpo extraño
- Sustancias exógenas: talco, suturas, restos vegetales…
- Sustancias endógenas: colesterol, calcio, pelos, úrico
- Células epitelioides + gigantes multinucleadas tipo cuerpo extraño
- Pocos linfocitos
-
Granulomas inmunitarios
- Agentes que inducen respuesta inmune celular
- Partículas difíciles de eliminar
- Ej.: micobacterias, actinobacilos, actinomicetos, nocardias, brucella…
Parasitarios:
- Siempre eosinófilos
Hongos:
- Siempre neutrófilos (piogranulomas)
TUBERCULOSIS (TBC) — Inflamación granulomatosa
- Micobacterias (M. tuberculosis, bovis, avium).
- Afecta a pulmón, linfonodos, serosas, hígado, riñón, intestino…
- Sin toxinas clásicas.
- Lesión causada por la respuesta inmune.

Lesiones:
- Tubérculo miliar (mm)
- Conglomerados (grandes)
- De Köster (microscópicos)
Estructura del tubérculo:
- Zona central de necrosis caseosa
- Células epitelioides
- Células gigantes de Langhans
- Corona de linfocitos
(Imágenes: tubérculo miliar, conglomerado, necrosis caseosa)
Clase del /
PARATUBERCULOSIS
- Mycobacterium avium subsp. paratuberculosis (Ziehl-Neelsen +).
- Rumiantes principalmente.
Lesiones:
- Enteritis crónica granulomatosa difusa
- Linfadenitis granulomatosa
(Imágenes: infiltrado difuso, atrofia de vellosidades, células gigantes, Ziehl +)
INFLAMACIÓN CRÓNICA NO GRANULOMATOSA
Predominio:
- Linfocitos y células plasmáticas
- Pocos macrófagos
Órganos afectados:
- Intestino: Enteritis linfoplasmocitarias
- Riñón: Nefritis intersticial crónica
- Pulmón: Neumonías intersticiales
- Encéfalo: Encefalitis linfoplasmocitarias
(Imágenes: nefritis intersticial crónica, neumonía intersticial crónica)
SIGNIFICACIÓN BIOLÓGICA
- Defensa frente a agentes irritantes persistentes y difíciles de degradar por macrófagos (parásitos, micobacterias, sílice…).
- Respuesta tras fracaso de la inflamación aguda.
- Intento de aislar, secuestrar o destruir el patógeno.

No comments to display
No comments to display